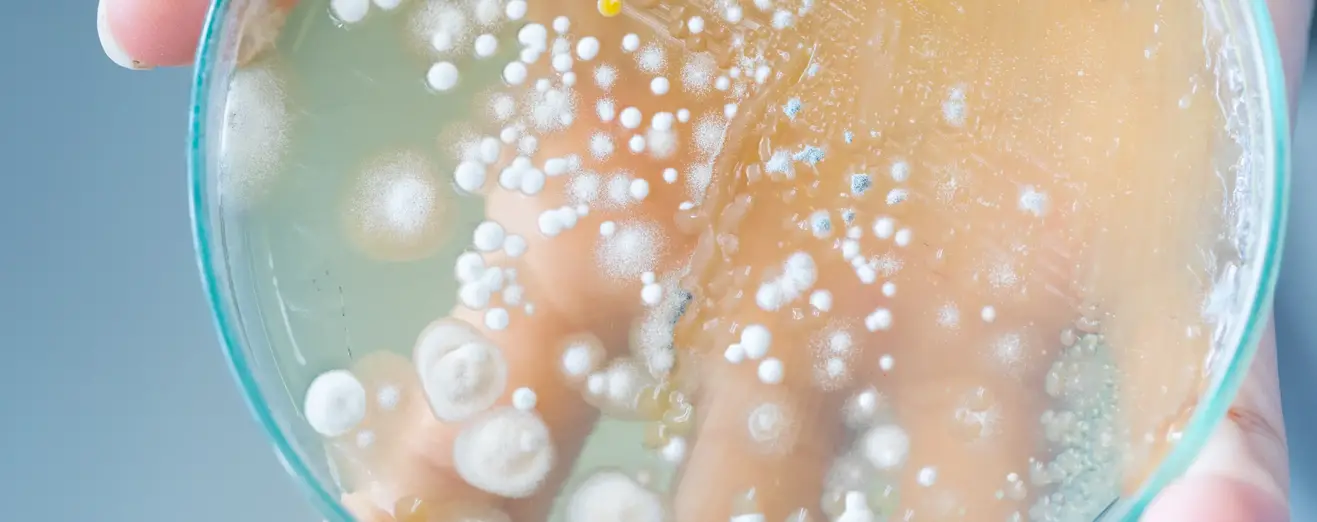
post-bg-727

CAR-T products as a promising BMCP on the territory of Russia and the EAEU
More than a year has passed since our latest publication dedicated to CAR-T therapy — cell products belonging to the BMCP category. Since then, the Russian Federation has introduced several normative legal acts regulating the process of registration of BMCP, and it would seem that the process of putting into circulation such high-tech products, slowly but surely acquires standardized forms, but by 2020 no product has entered the registration trail.
Meanwhile, many foreign and Russian companies are at the stage of discussion of the strategy of introduction of such drugs not only on the Russian market, but also in the EAEU. The desire of manufacturers is clear: BMCP entry to the market is a time-consuming and long process. In addition, registration of BMCP is not an easy task, as in the legislation of the EAEU, for example, there is no concept of BMCP. Within the EAEU, such products are called high-tech medicines (VTLP). In addition, the normative legal acts regulating the requirements for production, preclinical and clinical trials, the conduct of examinations and the procedure of state registration are significantly different.
Returning to the topic of CAR-T therapy, it should be noted that cellular products belonging to this category are one of the promising directions from the point of view of introduction into circulation in the territory of the Russian Federation and EAEU. For example, the Swiss company Novartis is currently negotiating with Russian regulators to register in Russia a drug for acute lymphoblastic leukemia and B-cell lymphoma — Kymriah.
Kymriah is a genetically modified autologous T cells capable of attacking tumor cells. The cell product is already registered in the US and the European Union, but is subject to close safety monitoring. Nevertheless, the Head of Biomedical Cell Products (BMCP) to the market in the region “Europe” claims that the drug helps to increase life expectancy: “For example, one of the first patients, Emily Whitehead, who received the drug in 2011, is still in remission.”
According to some estimates, the cost of treatment with Kymriah in 23 countries of the world, where access to the drug is provided by the state, is about 20 million rubles, but Novartis prefers to speak about the final cost of treatment in Russia after the end of the product registration.
Russia is also developing in the field of CAR-T therapy. For example, the pharmaceutical company “Biokad” together with NMIC them. Almazova has been developing a drug based on genetically modified T-lymphocytes since 2018. The cost of treatment of the developed drug is estimated at 16 million rubles. However, it is not hard to speak about the timing of the new product to the market of the Russian Federation and the EAEU.
It should be noted that NMIC of. Almazova is working in the field of BMCP in several areas: GMP production, reduction of the cost of CAR-T products, etc. However, the research center sees as a priority the development of allogenic CAR-T, because such a product is a standardized BMCP 10-100 times less in cost than autologous product. In addition, such a BMCP will be suitable for any patient with indications of the use of this type of therapy. More information about the difference between allogenic and autologous products can be found here.
"R-Pharm" Company and MSMU named after M. Sechenov also signed an agreement on the development of CAR-T method of therapy in 2018, but details about the development of the project could not be found.















